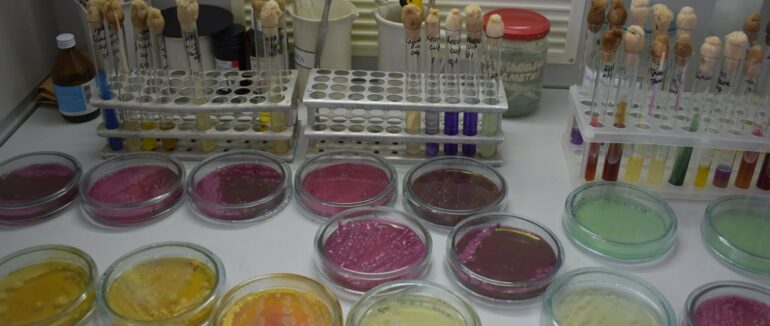
На Закарпатті у сирах з двох військових складів виявили бактерії кишкової палички

Результати цих досліджень виявили невідповідність за одним з показників, зокрема наявність у продукті бактерії групи кишкової палички (БГКП) в 0,01г
До Закарпатської регіональної державної лабораторії Держпродспоживслужби, за зверненням військової частини 1493 Державної прикордонної служби України, прикордонний загін (м. Чоп, вул. Головна, 55, а продовольчий склад №2) та військової частини 2142 прикордонний загін (м. Мукачево, вул. Маргітича, 31 продовольчий склад) надійшли зразки сиру твердого для проведення лабораторних досліджень на мікробіологічні показники.
Такі бактерії, хоч і не завжди, але можуть викликати гострі кишкові отруєння. Водночас вони вказують, що продукція може бути контамінована й іншою патогенною кишковою мікрофлорою. За типовим ростом на поживних середовищах, морфологічними та біохімічними ознаками, виявлені мікроорганізми є санітарно-показовими і належать до родини ентеробактерій – своєрідного маркера фекальної контамінації (лат. contaminatio – змішання, злиття).
Партію сиру вагою 1500 кг вилучили з обігу та, згідно із супровідними документами, повернули постачальнику.
Відповідно до листа в.о. директора Закарпатської регіональної лабораторії В’ячеслава Садварі, фахівці ГУ Держпродспоживслужби області встановили, що постачальник вказаної продукції зареєстрований за межами Закарпатської області: ТзОВ «СЕФТОРГ» вул. Лобача, 14, с. Калашники, Полтавський район, Полтавська область, 38753, реєстраційні номери потужностей оператора ринку r-UA-16-19-793, r-UA-16-19-794.
За декларацією виробника, цей сир виготовлений ТОВ «Іва Мілк» вул. Шкільна, 43,б, с. Кам’янка, Кам’янець-Подільський район, Хмельницької області, експлуатаційний дозвіл для потужностей з виробництва, переробки або реалізації харчових продуктів a-UA-22-08-103-IX-PP від 30.07.2020 року.
Тож спеціалісти ГУ ДПСС Закарпаття направили листи до ГУ Держпродспоживслужби у Полтавській та Хмельницькій областях з інформацією про виявлену невідповідність та для реагування у межах чинного законодавства, передає Головне управління Держпродспоживслужби в Закарпатській області.